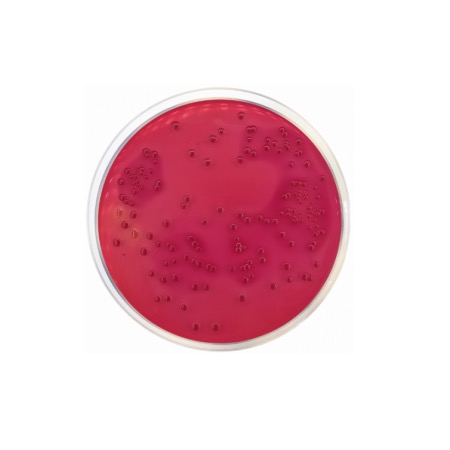

This medium is a modification of the original Desoxycholate Agar, specifically balanced for the recovery of coliforms. It contains Sodium Desoxycholate at a concentration that inhibits Gram-positive bacteria without being overly toxic to enteric Gram-negative rods. Peptone Mixture and Meat Extract provide the necessary nitrogen, vitamins, and minerals for growth. Lactose is the fermentable carbohydrate, and Neutral Red serves as the pH indicator. When lactose is fermented, the resulting acid production causes the colonies to turn pink or red. A secondary reaction occurs where the acid environment causes the desoxycholate to precipitate, often appearing as a zone of cloudiness around the colony. Non-lactose fermenters, such as Salmonella and Shigella, appear as colorless or transparent colonies.
Advantages
- Excellent Differentiation: Provides high contrast between lactose fermenters (red) and non-lactose fermenters (colorless), simplifying presumptive identification.
- Optimized for Coliforms: Specifically formulated to support the enumeration of E. coli and Klebsiella species in food and water.
- Moderate Selectivity: Effective suppression of Gram-positive contaminants while ensuring high recovery rates of potentially stressed enteric bacteria.
- Pour-Plate Compatible: Ideal for enumeration techniques in the dairy industry, allowing for clear visualization of deep colonies.
- Reliable Indicator: The Neutral Red indicator provides stable and consistent color changes throughout the incubation period.
Technical specifications
| Catalogue number |
1025 |
| Brand |
Condalab |
| Application |
Enumeration of coliforms / Differentiation of enteric pathogens |
| Typical Composition (g/L) |
Peptone Mixture (10.0); Meat Extract (3.0); Lactose (10.0); Sodium Desoxycholate (0.5); Sodium Chloride (5.0); Sodium Citrate (2.0); Neutral Red (0.03); Bacteriological Agar (12.0) |
| Final pH (at 25 °C) |
7.1 ± 0.2 |
| Preparation |
42.5 g/L (Do not autoclave) |
| Storage Temperature |
2 – 25 °C |
Available packaging options
| 1025 |
500 g plastic bottle |